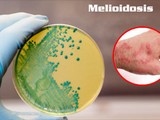
Chuyên gia vi sinh của Đại học Y Hà Nội: Không dễ mắc bệnh Whitmore

Theo Sở Y tế TP. Hà Nội, tình hình dịch bệnh truyền nhiễm năm 2019 tại Hà Nội ổn định, không ghi nhận các trường hợp mắc các bệnh đặc biệt nguy hiểm, hầu hết các bệnh có số mắc giảm, một số dịch bệnh lưu hành có số mắc tăng như sốt xuất huyết, sởi nhưng đã được khống chế kịp thời, không xảy ra dịch lớn và không có tử vong.
Thống kê cho thấy, trong năm 2019, toàn TP. Hà Nội có 12.179 trường hợp mắc sốt xuất huyết, 1.764 trường hợp mắc sởi, 1.045 trường hợp mắc tay chân miệng; 117 trường hợp ho gà và không có trường hợp tử vong.
Toàn thành phố có 1 trường hợp mắc liên cầu lợn, 4 trường hợp viêm não Nhật Bản, 3 trường hợp viêm não mô cầu, 15 trường hợp mắc uốn ván ở người lớn.
Đáng chú ý, đến thời điểm hiện tại, toàn thành phố đã phát hiện hơn 21.000 trường hợp mắc, nghi mắc các bệnh truyền nhiễm.
Trước tình hình nhiều dịch bệnh truyền nhiễm có nguy cơ bùng phát trong thời gian tới, từ cuối năm 2018, Sở Y tế TP. Hà Nội đã tham mưu để UBND thành phố ban hành kế hoạch phòng chống dịch bệnh trên địa bàn thành phố năm 2019.
Ban chỉ đạo phòng chống dịch thành phố đã tổ chức giao ban đánh giá kết quả phòng chống dịch thường xuyên, đột xuất để nắm bắt tình hình dịch bệnh, triển khai các biện pháp phòng chống dịch bệnh kịp thời đối với các bệnh như sốt xuất huyết, sởi, tay chân miệng.
Cùng với công tác lãnh đạo, chỉ đạo, hệ thống giám sát dịch từ thành phố đến cơ sở đã tiếp tục được củng cố, tăng cường về nhân lực và nâng cao về trình độ chuyên môn, thực hiện giám sát chủ động tại 63 bệnh viện từ trung ương, bộ, ngành đến quận, huyện.